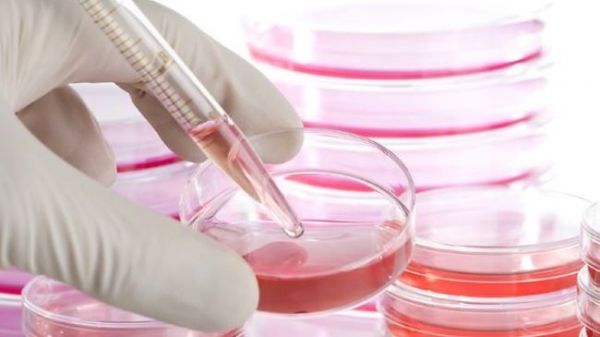

Estamos en las redes sociales -
Células madre genéticamente modificados contra el cáncer cerebral
Un equipo de científicos de la Escuela de Medicina de Harvard, según los informes, ha encontrado una manera eficaz de convertir células madre en herramientas que reprimen el cáncer de cerebro. Durante un experimento que se llevó a cabo en sujetos animales, los científicos hicieron uso de células madre que fueron diseñados genéticamente para producir y liberar toxinas que específicamente dirigidos tumores cerebrales sin afectar a las células normales circundantes. Con los prometedores resultados que se produjeron, el equipo tiene la esperanza de que el siguiente paso de este procedimiento de avance es las pruebas en humanos.
Este estudio es el producto de muchos años de investigación que se puso en la búsqueda de una terapia basada en células madre que podría ser utilizado contra el cáncer. Los expertos se mostraron optimistas de que serían capaces de llegar a una manera de matar las células cancerosas en los tumores sin dañar a las células circundantes. Las células madre genéticamente modificados utilizados en este procedimiento fueron capaces de secretar el cáncer esencial matar toxinas, pero eran únicamente resistentes a los efectos nocivos del veneno que produjeron.
Durante la fase de ensayos en animales del estudio, las células madre fueron infundidas en el sitio del tumor extirpado utilizando una matriz basada en gel. Una vez administrado, las células madre liberadas las toxinas y las células de cáncer en las cercanías murieron porque estaban indefensos contra la acción de la toxina. El autor principal, el Dr. Khalid Shah, dijo que el equipo está muy contento con el resultado positivo que han logrado.
"Después de hacer todos los análisis molecular y de imagen para realizar un seguimiento de la inhibición de la síntesis de proteínas dentro de los tumores cerebrales, hacemos ver las toxinas matan toxinas. Causantes de cáncer de las células del cáncer se han utilizado con gran éxito en una variedad de cánceres de la sangre, pero ellos no funciona tan bien en tumores sólidos debido a que los cánceres no son tan accesibles, y las toxinas tienen una vida media corta, "dijo.
Añadió que la ingeniería genética fue capaz de modificar las células madre para ser capaz de hacer todo esto, diciendo: "Ahora, tenemos células madre de resistencia toxina que puede producir y liberar el cáncer matando a las drogas."
Los resultados del estudio fueron publicados en la revista Células Madre, y detalla la investigación fue un esfuerzo conjunto de la Universidad de Harvard Stem Cell Institute y el Hospital General de Massachusetts.
Artículos relacionados "Células madre genéticamente modificados contra el cáncer cerebral"
Por favor, evaluar este artículo
Recomendado
Interesante